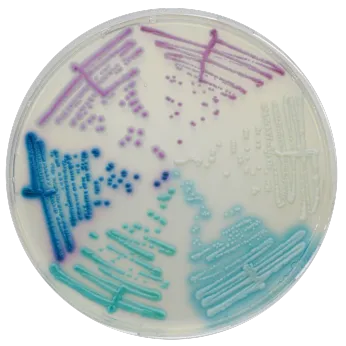

CHROMagar Microbiology
Exhibitors
Information
CHROMagar™ provides innovative, rapid and efficient chromogenic culture media solutions, designed to improve and simplify traditional culture techniques.
Founded in 1993 by Dr Alain Rambach, the inventor and pioneer in chromogenic culture media technology, we supply the widest range of available dehydrated chromogenic culture media.
Our solutions cover applications in clinical routine bacteriology as well as infection control protocols for the detection of antimicrobial-resistant microorganisms.
Research-driven and high-tech, CHROMagar™ leads the innovation in the field of chromogenic culture media technology with an international reach through its worldwide distribution network.